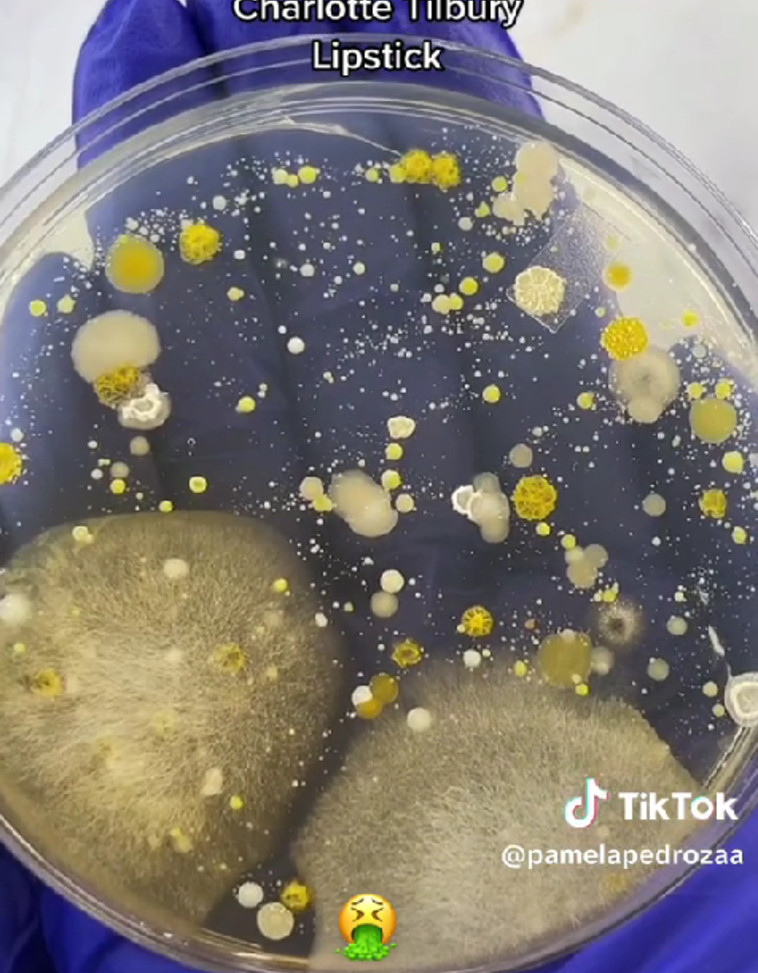
גידולי חיידקים מבחילים בטסטרים של איפור

בתגובות, הגולשים נחרדו כשראו במו עיניהם מה מסתתר בטסטרים, והסבירו כי היו מודעים לעובדה שהפריטים בוודאי לא היגייניים במיוחד, אך לא דמיינו שהם מזוהמים עד כדי כך. היו גם כמה מגיבים שחשפו כי במקום עבודתם, הם מבקשים מהלקוחות שלא להשתמש בטסטרים ישירות על עור הפנים. אחת מהם כתבה: "ואז כועסים עלינו כשאנחנו מבקשים לא להשתמש בטסטרים. עכשיו תבינו למה".